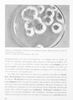

- ΙΕΠ
- Σχολικό Εγχειρίδιο
- Β' Λυκείου
Ιωάννης Θ. Παπαβασιλείου
Υγιεινή Β΄ Λυκείου
[1980, 12η Έκδοση]
Σχολικό εγχειρίδιο Υγιεινής για τη Β΄ Λυκείου που εστιάζει περιβαντολλογική διάσταση της υγιεινής, τα λοιμώδη νοσήματα, και την κοινωνική υγιεινή.
- ΠΕΔΙΟ ΑΝΑΓΝΩΡΙΣΗΣ »
- ΠΕΔΙΟ ΠΕΡΙΕΧΟΜΕΝΟΥ »
- ΠΕΔΙΟ ΠΛΗΡΟΦΟΡΙΩΝ ΕΚΔΟΣΗΣ »
- ΠΕΔΙΟ ΠΑΡΑΤΗΡΗΣΕΩΝ »
- ΕΥΡΕΤΗΡΙΟ ΘΕΜΑΤΙΚΩΝ ΟΡΩΝ »
| TopΠΕΔΙΟ ΑΝΑΓΝΩΡΙΣΗΣ |
|---|
Κωδικός αναγνώρισης: 01-19835 Τίτλος: Υγιεινή Β΄ Λυκείου Συγγραφέας: Ιωάννης Θ. Παπαβασιλείου Μέγεθος και υπόστρωμα: Σχολικό εγχειρίδιο, 20εκ., μαλακό εξώφυλλο, 135 σελίδες. |
| TopΠΕΔΙΟ ΠΕΡΙΕΧΟΜΕΝΟΥ |
Βαθμίδα εκπαίδευσης: Δευτεροβάθμια Τάξη: Β' Λυκείου Μάθημα: Υγιεινή Γλώσσα: Δημοτική Παρουσίαση περιεχομένου: Σχολικό εγχειρίδιο Υγιεινής για τη Β΄ Λυκείου που εστιάζει περιβαντολλογική διάσταση της υγιεινής, τα λοιμώδη νοσήματα, και την κοινωνική υγιεινή. |
| TopΠΕΔΙΟ ΠΛΗΡΟΦΟΡΙΩΝ ΕΚΔΟΣΗΣ |
Εκδότης: Οργανισμός Εκδόσεως Διδακτικών Βιβλίων Έτος έκδοσης: 1980 Τόπος έκδοσης: Αθήνα Έκδοση: 12η Υπουργική απόφαση / Σύμβαση: 3346/18-1-1980 Έτος έγκρισης: 1980 |
| TopΠΕΔΙΟ ΠΑΡΑΤΗΡΗΣΕΩΝ |
Εντοπισμός πρωτοτύπου: Ινστιτούτο Εκπαιδευτικής Πολιτικής Κωδικός βιβλιοθήκης: 19835 |
| TopΕΥΡΕΤΗΡΙΟ ΘΕΜΑΤΙΚΩΝ ΟΡΩΝ |
Σχετιζόμενα πρόσωπα: Σχετιζόμενοι όροι: |
LDR 01151 2200217 4500
035 ## _a01-19835
040 ## _aΙνστιτούτο Εκπαιδευτικής Πολιτικής
041 ## _ael
100 ## _aΙωάννης Θ. Παπαβασιλείου
110 ## _a19835
245 0# _aΥγιεινή Β΄ Λυκείου
250 ## _a12η Έκδοση
260 ## _aΑθήνα
_bΟργανισμός Εκδόσεως Διδακτικών Βιβλίων
_c1980
300 ## _a135
_c20
520 ## _aΣχολικό εγχειρίδιο Υγιεινής για τη Β΄ Λυκείου που εστιάζει περιβαντολλογική διάσταση της υγιεινής, τα λοιμώδη νοσήματα, και την κοινωνική υγιεινή.
521 ## _aΒ' Λυκείου
522 ## _aΕλλάδα
546 ## _aΔημοτική
563 ## _aΜαλακό Εξώφυλλο
583 ## _a3346/18-1-1980
_c1980
650 #4 _aΑκτινοβολία
_aΑποχέτευση
_aΑτμόσφαιρα
_aΕπιδημίες επαγγελματική και δημόσια υγιεινή
_aΙατρική της εργασίας
_aΜόλυνση